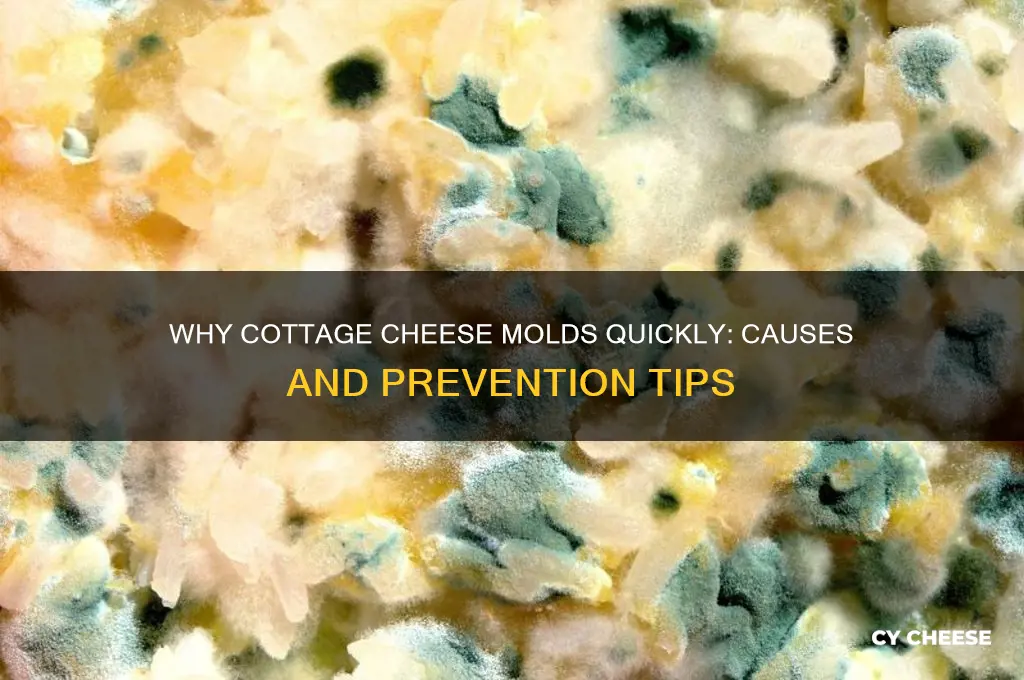
why did my cottage cheese get moldy so fast

Cottage cheese, like many dairy products, is highly perishable and can spoil quickly under certain conditions. If your cottage cheese developed mold faster than expected, several factors could be at play. Improper storage, such as leaving it unrefrigerated or exposing it to warmer temperatures, accelerates bacterial growth. Cross-contamination from utensils or hands can introduce mold spores, while a damaged or improperly sealed container may allow air and moisture to enter, fostering mold development. Additionally, exceeding the product’s expiration date or purchasing it close to its sell-by date increases the risk of spoilage. Understanding these factors can help you take preventive measures to keep your cottage cheese fresh longer.
| Characteristics | Values |
|---|---|
| Improper Storage | Exposure to air, improper sealing, or storing at room temperature can accelerate mold growth. Cottage cheese should be kept refrigerated at or below 40°F (4°C). |
| Expired Product | Consuming cottage cheese past its expiration date increases the risk of mold, as natural preservatives lose effectiveness over time. |
| Contamination | Cross-contamination from utensils, hands, or other foods can introduce mold spores into the cottage cheese. |
| Damaged Packaging | Torn or punctured packaging allows mold spores from the environment to enter and grow on the cheese. |
| High Moisture Content | Cottage cheese's high moisture level creates an ideal environment for mold growth, especially if not stored properly. |
| Lack of Preservatives | Some cottage cheese varieties contain fewer preservatives, making them more susceptible to mold growth. |
| Exposure to Light | Prolonged exposure to light can degrade packaging and promote mold growth. Store cottage cheese in opaque containers or in a dark place. |
| Temperature Fluctuations | Frequent temperature changes, such as moving cottage cheese in and out of the refrigerator, can encourage mold development. |
| Poor Hygiene | Inadequate cleaning of storage containers or refrigerator shelves can lead to mold growth on cottage cheese. |
| Natural Mold Spores | Mold spores are naturally present in the environment and can settle on cottage cheese, especially if it's not sealed properly. |
Explore related products
What You'll Learn
- Improper storage conditions: temperature, humidity, and air exposure impact mold growth
- Expired or damaged packaging: compromised seals or past expiration dates accelerate spoilage
- Cross-contamination: exposure to mold spores from other foods or utensils
- High moisture content: excess liquid in cottage cheese promotes mold development
- Weakened preservatives: reduced effectiveness of natural or added preservatives in the product

Improper storage conditions: temperature, humidity, and air exposure impact mold growth
Cottage cheese, like many dairy products, is highly perishable and susceptible to mold growth if not stored properly. Improper storage conditions, particularly related to temperature, humidity, and air exposure, play a significant role in how quickly mold develops. Understanding these factors can help you extend the shelf life of your cottage cheese and prevent spoilage.
Temperature is one of the most critical factors in cottage cheese storage. Cottage cheese should always be stored in the refrigerator at a consistent temperature of 35°F to 40°F (2°C to 4°C). If the temperature fluctuates or rises above this range, it creates an ideal environment for mold spores to thrive. For example, leaving cottage cheese out at room temperature, even for a short period, can accelerate mold growth. Similarly, storing it in the refrigerator door, where temperatures are less stable due to frequent opening and closing, increases the risk. Always store cottage cheese in the coldest part of the refrigerator, such as the back shelf, to maintain a steady temperature.
Humidity is another key factor that impacts mold growth. Cottage cheese containers are often sealed to prevent moisture loss, but once opened, exposure to high humidity can introduce mold spores. Additionally, if the refrigerator itself is humid, condensation can form on the container, creating a damp environment that mold thrives in. To mitigate this, ensure the cottage cheese container is tightly sealed after each use and consider using a dehumidifier in the refrigerator if humidity is a recurring issue. Storing cottage cheese in a dry, airtight container can also help reduce moisture-related mold growth.
Air exposure is often overlooked but is equally important in preventing mold. Once cottage cheese is opened, it is exposed to air, which contains mold spores. Prolonged exposure increases the likelihood of these spores settling on the cheese and growing. To minimize air exposure, press a piece of plastic wrap directly onto the surface of the cottage cheese before sealing the container. This creates a barrier that reduces the amount of air in contact with the cheese. Additionally, avoid using utensils that have been in contact with other foods, as they can introduce mold spores or bacteria.
In summary, improper storage conditions—specifically temperature, humidity, and air exposure—are primary contributors to mold growth in cottage cheese. By maintaining a consistent refrigerator temperature, controlling humidity, and minimizing air exposure, you can significantly reduce the risk of mold and enjoy your cottage cheese for longer. Always follow storage guidelines and inspect the cheese for any signs of spoilage before consumption.
Cottage Cheese vs. Paneer: Understanding the Key Differences and Similarities
You may want to see also

Expired or damaged packaging: compromised seals or past expiration dates accelerate spoilage
Cottage cheese, like many dairy products, is highly perishable and relies heavily on proper packaging to maintain its freshness. Expired or damaged packaging is a significant factor in why your cottage cheese might have molded quickly. Once the packaging is compromised—whether through a broken seal, puncture, or being past its expiration date—the protective barrier against bacteria, mold, and other contaminants is lost. This allows moisture to escape and external microorganisms to enter, creating an ideal environment for mold growth. Always check the packaging for any signs of damage before purchasing or consuming cottage cheese.
A compromised seal is one of the most common issues with packaging. Cottage cheese containers are designed with airtight seals to prevent oxygen and bacteria from entering. If the seal is cracked, loose, or improperly closed, air can infiltrate the container, accelerating spoilage. Similarly, if the container has been dropped or mishandled, the seal may become damaged without visible signs. To avoid this, inspect the lid and edges of the container for any irregularities or gaps before opening. If the seal appears tampered with or weak, it’s best to discard the product.
Another critical aspect is the expiration date. Cottage cheese has a limited shelf life, and consuming it past this date significantly increases the risk of mold and other spoilage. Expiration dates are determined based on optimal freshness and safety, and exceeding this timeframe allows bacteria and mold to multiply rapidly, even if the packaging appears intact. Always check the "best by" or "use by" date on the label and adhere to it strictly. If the cottage cheese is nearing or past its expiration date, it’s safer to dispose of it rather than risk consuming spoiled product.
Damaged packaging, such as dents, punctures, or tears, can also contribute to rapid mold growth. Even small breaches in the container can allow mold spores or bacteria to enter and thrive. Additionally, damaged packaging may cause the cottage cheese to dry out or become exposed to temperature fluctuations, further accelerating spoilage. When shopping, carefully inspect the packaging for any visible damage and avoid purchasing products with compromised containers. Proper handling during transportation and storage is equally important to prevent accidental damage.
In summary, expired or damaged packaging plays a crucial role in the rapid spoilage of cottage cheese. Compromised seals, past expiration dates, and physical damage to the container all create conditions conducive to mold growth. To prevent this, always inspect the packaging for integrity, adhere to expiration dates, and handle the product with care. By taking these precautions, you can significantly reduce the likelihood of your cottage cheese molding prematurely and ensure a safer, fresher consumption experience.
Cottage Cheese and Tomatoes: Calorie Count and Nutritional Benefits
You may want to see also

Cross-contamination: exposure to mold spores from other foods or utensils
Cottage cheese can develop mold faster than expected due to cross-contamination, which occurs when mold spores from other foods or utensils come into contact with the cheese. Mold spores are microscopic and omnipresent in the environment, but they thrive in moist, nutrient-rich conditions like those found in dairy products. If your cottage cheese container or utensils have been exposed to moldy items, these spores can transfer and accelerate mold growth. For example, using a spoon that previously touched moldy bread or jam can introduce spores directly into the cheese. Even if the cheese itself is fresh, these external spores can quickly colonize and cause visible mold within days.
To prevent cross-contamination, it’s crucial to use clean utensils when handling cottage cheese. Always wash spoons, knives, or other tools with hot, soapy water before and after use, especially if they’ve been in contact with other foods. Avoid using the same utensils for multiple items without cleaning them in between. Additionally, ensure that the container or lid of the cottage cheese is free from mold or residue, as spores can linger on surfaces and contaminate the cheese when closed. Regularly inspect your utensils and storage containers for signs of mold, and replace them if necessary.
Another common source of cross-contamination is storing cottage cheese near mold-prone foods in the refrigerator. Mold spores can travel through the air, especially in confined spaces like a fridge. Keep cottage cheese away from items like fruits, bread, or other cheeses that are more likely to develop mold. Use airtight containers or seal the cottage cheese properly to minimize exposure to airborne spores. If you notice mold on any food item in your fridge, remove it immediately to prevent spores from spreading to other foods, including cottage cheese.
Proper hygiene practices in the kitchen also play a significant role in preventing cross-contamination. Wash your hands thoroughly before handling cottage cheese or any food, as mold spores can transfer from your skin. Clean your refrigerator regularly, paying special attention to shelves and drawers where moldy foods may have been stored. Wipe down surfaces with a solution of water and vinegar, which can help kill mold spores and prevent their spread. By maintaining a clean kitchen environment, you reduce the risk of mold spores coming into contact with your cottage cheese.
Lastly, be mindful of the condition of other foods in your pantry or fridge. Moldy items like berries, bread, or condiments can be silent culprits in cross-contamination. Regularly check your food supplies and discard anything showing signs of mold. If you’ve recently dealt with moldy food, take extra precautions when handling cottage cheese, as spores may still be present in the area. By staying vigilant and adopting these preventive measures, you can significantly reduce the likelihood of your cottage cheese becoming moldy due to cross-contamination.
Cottage Cheese Price Guide: Affordable Options in the Philippines
You may want to see also
Explore related products

High moisture content: excess liquid in cottage cheese promotes mold development
Cottage cheese's susceptibility to mold is often directly linked to its high moisture content. Unlike harder cheeses that have a lower water activity, cottage cheese retains a significant amount of liquid, both in its curds and the surrounding whey. This excess moisture creates an ideal environment for mold spores to thrive. Mold requires water to grow, and the high moisture level in cottage cheese provides the necessary hydration for spores to germinate and spread rapidly. Therefore, the more liquid present, the greater the risk of mold development.
The excess liquid in cottage cheese not only supports mold growth but also accelerates it. Mold spores are naturally present in the air and can easily land on food surfaces. When these spores encounter the moist environment of cottage cheese, they absorb water and begin to multiply. The whey, which is the liquid component of cottage cheese, acts as a nutrient-rich medium for mold. As mold colonies grow, they release enzymes that break down the cheese further, releasing more moisture and creating a self-perpetuating cycle of mold development. This process is expedited in cottage cheese due to its inherently high water content.
To mitigate mold growth caused by high moisture content, proper storage practices are essential. Cottage cheese should be stored in airtight containers to minimize exposure to airborne mold spores. Additionally, it is crucial to drain excess whey before refrigerating the cheese. By reducing the amount of liquid, you lower the water activity, making it less hospitable for mold. However, even with these measures, cottage cheese's natural moisture level still poses a risk, and it should be consumed within a few days of opening to prevent mold from taking hold.
Another factor contributing to mold development is temperature. Cottage cheese should always be refrigerated at or below 40°F (4°C), as mold grows more slowly at colder temperatures. Warmer conditions, such as leaving cottage cheese at room temperature, significantly increase the rate of mold growth due to the combination of high moisture and favorable temperatures. Even brief exposure to warmer environments can introduce mold spores and accelerate their proliferation, making proper refrigeration critical for extending the cheese's shelf life.
Lastly, understanding the role of moisture in mold growth highlights the importance of checking cottage cheese for signs of spoilage regularly. If excess liquid is visible, it should be carefully drained, and the cheese inspected for any moldy spots. While small amounts of mold can sometimes be removed from harder cheeses, cottage cheese's soft texture and high moisture content make it unsafe to consume once mold appears. Discarding moldy cottage cheese is the safest option, as mold can produce harmful toxins that spread throughout the food, even if visible mold is removed. By addressing high moisture content through proper storage and handling, you can significantly reduce the likelihood of mold developing in cottage cheese.
Where to Find Dean's Cottage Cheese: A Comprehensive Guide
You may want to see also

Weakened preservatives: reduced effectiveness of natural or added preservatives in the product
Cottage cheese, like many dairy products, relies on preservatives—both natural and added—to inhibit the growth of mold and other microorganisms. However, if these preservatives are weakened or less effective, mold can develop rapidly. Natural preservatives in cottage cheese include lactic acid, produced during fermentation, which lowers the pH and creates an environment hostile to most bacteria and fungi. Added preservatives, such as natamycin or potassium sorbate, further extend shelf life by targeting specific microbial pathways. If these preservatives are compromised, either due to improper formulation, storage, or manufacturing processes, their ability to suppress mold growth diminishes significantly.
One common reason for weakened preservatives is exposure to improper storage conditions. Cottage cheese requires refrigeration at temperatures below 40°F (4°C) to maintain the efficacy of its preservatives. If the cheese is left at room temperature or exposed to temperature fluctuations, the preservatives can degrade or become less active. For example, lactic acid’s effectiveness decreases as the pH rises, which can happen if the cheese warms up, allowing mold spores to thrive. Similarly, added preservatives like natamycin lose potency when exposed to heat or moisture, rendering them ineffective against mold.
Another factor contributing to weakened preservatives is the presence of contaminants during production. If the cottage cheese is not made in a sterile environment, bacteria or mold spores can introduce enzymes that break down preservatives. For instance, certain bacteria produce enzymes capable of neutralizing lactic acid or degrading added preservatives. Additionally, if the preservatives are not evenly distributed throughout the product, pockets of lower preservative concentration can become breeding grounds for mold. This uneven distribution often occurs when the cheese is not properly mixed during manufacturing.
The type and quality of preservatives used also play a critical role. Some manufacturers may opt for lower-cost or less effective preservatives to cut expenses, which can result in inadequate protection against mold. Natural preservatives, while generally safer, may not be as potent as synthetic ones and require precise conditions to work optimally. If the balance of preservatives is off—for example, too little natamycin or an insufficient pH level—mold can take hold quickly. Consumers should check product labels for preservative types and ensure they are purchasing from reputable brands that prioritize quality.
Finally, the age of the cottage cheese and its proximity to the expiration date can impact preservative effectiveness. Over time, preservatives naturally break down, reducing their ability to inhibit mold growth. If the cheese is consumed close to or past its expiration date, the preservatives may no longer be potent enough to prevent spoilage. To avoid this, always check the expiration date and consume the product well before it expires. Proper storage and handling, such as using clean utensils and sealing the container tightly, can also help maintain preservative efficacy and delay mold formation.
Creamy Avocado Cottage Cheese Dip: Easy, Healthy Recipe to Make
You may want to see also
Frequently asked questions
Cottage cheese can mold quickly due to exposure to air, improper storage, or contamination from utensils or containers.
Store cottage cheese in the refrigerator at or below 40°F (4°C), keep it in an airtight container, and avoid double-dipping utensils to prevent contamination.
No, it’s unsafe to eat cottage cheese with mold, as harmful bacteria may be present even if the mold is removed.
No, the expiration date is a guideline for freshness, but improper handling or storage can cause mold to develop before the date.

























